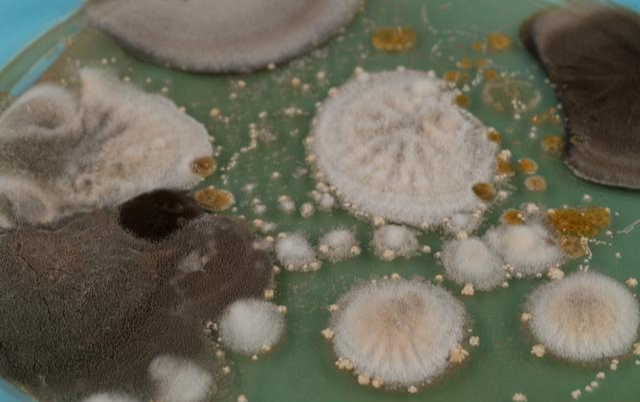

南极是地球上最寒冷、最干燥、最偏远的大陆,也是人类探索的最后一片边疆。在这片冰雪覆盖的土地上,隐藏着许多未知的生命奥秘。最近,中国科学家在南极冰川中发现了一种新的微生物,它们可以在极端低温和高盐度的环境中生存,为我们揭示了地球上生命的起源和多样性,也为寻找外星生命提供了新的线索。


微生物是指那些肉眼看不见,只能用显微镜观察到的生物,包括细菌、古菌、真核生物和病毒等。微生物是地球上最早出现和最广泛分布的生命形式,它们在自然界中扮演着重要的角色,参与着各种物质和能量的循环。微生物也是地球上最适应力强的生命形式,它们可以在极端的环境中存活,比如高温、高压、高辐射、低氧、低营养等。


南极冰川就是这样一个极端的环境,它们是由降雪经过长期累积和压缩而形成的巨大冰块,覆盖了南极大陆的大部分面积。南极冰川中有许多裂缝和空洞,里面充满了水。这些水可能来自于冰川表面或底部的融化,也可能来自于地下水或降雨。这些水构成了南极冰川中的水生态系统,其中蕴藏着丰富的微生物。


中国科学家在南极冰川中发现了一种新的微生物,它们属于古菌门中的嗜盐古菌纲。古菌是一种与细菌和真核生物不同的微生物域,它们有着独特的细胞结构和代谢方式。嗜盐古菌是指那些可以在高盐度环境中生存的古菌,它们可以利用光合作用或化学合成作用来获取能量。中国科学家发现的这种新型嗜盐古菌被命名为南极嗜盐古菌1号(Antarctic Halarchaeum sp. 1),它们可以在-20℃到-5℃之间的温度范围内生长,并且可以耐受高达30%的盐度。

南极嗜盐古菌1号是如何在这样恶劣的环境中存活呢?科学家发现,它们具有一些特殊的适应机制。首先,它们可以利用一种名为胞外多糖(EPS)的物质来保护自己免受低温和高盐度的伤害。EPS是一种由糖分子组成的多聚物,可以形成一层胶状的外壳,包裹在古菌的细胞壁外面。EPS可以防止水分流失,增加细胞的稳定性,也可以抵抗外界的物理和化学干扰。其次,它们可以利用一种名为甘油(glycerol)的物质来调节自己的渗透压。


甘油是一种有机化合物,可以作为古菌的能量储备和渗透压调节剂。当古菌遇到高盐度环境时,它们会在细胞内积累甘油,以保持与外界的渗透压平衡,防止细胞收缩或破裂。最后,它们可以利用一种名为色素蛋白(pigment protein)的物质来吸收光能。色素蛋白是一种含有色素分子的蛋白质,可以在光照下发生光化学反应,产生一种名为ATP的能量分子。ATP是古菌进行各种生命活动所必需的能量来源。色素蛋白可以让古菌在没有氧气和有机物的情况下,利用光合作用来获取能量。


南极嗜盐古菌1号的发现,为我们揭示了南极冰川中微生物的多样性和复杂性,也为我们探究地球上生命的起源和演化提供了新的思路。科学家认为,地球上最早出现的生命可能就是类似于古菌这样的微生物,它们可以在极端环境中存活,并且具有独特的代谢方式。南极冰川中的微生物可能是地球上最原始和最古老的生命形式之一,它们可能保留了地球上生命最初的特征和信息。通过研究南极冰川中的微生物,我们可能可以还原地球上生命最初的面貌,也可以推测其他类似环境中可能存在的生命形式。


南极冰川微生物的奥秘还有很多等待我们去发现和解读。对于极地微生物的科学探索,不仅可以增进我们对地球上生命多样性和复杂性的认识,也可以推动基础研究和应用研究的进步。例如,通过研究极地微生物如何适应低温和高盐度等环境因素,我们可能可以开发出新型的抗寒、抗盐、抗干旱等耐受性强的农作物品种,从而提高农业生产效率和质量。同时,通过研究极地微生物如何利用光合作用或化学合成作用来获取能量,我们可能可以开发出新型的清洁能源技术,从而减少对化石能源的依赖和对环境的污染。


保护和认识极地微生物很有意义,但也面临着许多挑战和困难。首先,南极的多聚物,可以形成一层胶状的外壳,包裹在古菌的细胞壁外面。EPS可以防止水分流失,增加细胞的稳定性,也可以抵抗外界的物理和化学干扰。其次,它们可以利用一种名为甘油(glycerol)的物质来调节自己的渗透压。甘油是一种有机化合物,可以作为古菌的能量储备和渗透压调节剂。


当古菌遇到高盐度环境时,它们会在细胞内积累甘油,以保持与外界的渗透压平衡,防止细胞收缩或破裂。最后,它们可以利用一种名为色素蛋白(pigment protein)的物质来吸收光能。色素蛋白是一种含有色素分子的蛋白质,可以在光照下发生光化学反应,产生一种名为ATP的能量分子。ATP是古菌进行各种生命活动所必需的能量来源。色素蛋白可以让古菌在没有氧气和有机物的情况下,利用光合作用来获取能量。


南极嗜盐古菌1号的发现,为我们揭示了南极冰川中微生物的多样性和复杂性,也为我们探究地球上生命的起源和演化提供了新的思路。科学家认为,地球上最早出现的生命可能就是类似于古菌这样的微生物,它们可以在极端环境中存活,并且具有独特的代谢方式。南极冰川中的微生物可能是地球上最原始和最古老的生命形式之一,它们可能保留了地球上生命最初的特征和信息。通过研究南极冰川中的微生物,我们可能可以还原地球上生命最初的面貌,也可以推测其他类似环境中可能存在的生命形式。


南极冰川微生物的奥秘还有很多等待我们去发现和解读。对于极地微生物的科学探索,不仅可以增进我们对地球上生命多样性和复杂性的认识,也可以推动基础研究和应用研究的进步。例如,通过研究极地微生物如何适应低温和高盐度等环境因素,我们可能可以开发出新型的抗寒、抗盐、抗干旱等耐受性强的农作物品种,从而提高农业生产效率和质量。同时,通过研究极地微生物如何利用光合作用或化学合成作用来获取能量,我们可能可以开发出新型的清洁能源技术,从而减少对化石能源的依赖和对环境的污染。 保护和认识极地微生物很有意义,但也面临着许多挑战和困难。


首先,南极是一个非常遥远和艰苦的地方,要到达那里并进行科学考察,需要付出巨大的物力和人力。其次,南极冰川中的微生物非常微小和隐蔽,要采集和分析它们,需要高精尖的仪器和技术。最后,南极冰川中的微生物也面临着环境变化和人为干扰的威胁,比如全球变暖导致的冰川融化,以及人类活动带来的污染和破坏。因此,我们应该加强对南极冰川中微生物的保护和研究,让这些神秘而珍贵的生命得到尊重和关爱。
